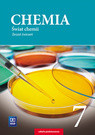
okładka Chemia świat chemii zeszyt ćwiczeń dla klasy 7 szkoły podstawowej 176802 książka | Dorota Lewandowska, Anna Warchoł

Opis treści
Zeszyt ćwiczeń do klasy 7 jest doskonałym uzupełnieniem podręcznika. Wszystkie tytuły działów i rozdziałów są takie same jak w książce. 1. Rodzaje i przemiany materii 2. Budowa materii 3. Wiązania i reakcje chemiczne 4. Gazy 5. Woda i roztwory wodne Zamieszczone w zeszycie ćwiczenia i zadania mają zróżnicowany stopnień trudności i umożliwiają pracę z uczniami na różnych poziomach. Porządkują i utrwalają zdobyte na lekcji wiadomości i umiejętności. Część zadań została zgrupowana w bloki Chemiczne rachunki – pozwalają one trenować wykonywanie obliczeń chemicznych. Każdy dział rozpoczyna się tabelą umiejętności, która ma pomóc uczniowi w planowaniu pracy oraz w dokonaniu samooceny. Zawiera ona wykaz wymagań edukacyjnych, sformułowanych zgodnie z podstawą programową. Na końcu każdego działu znajdują się zadania podsumowujące, które warto rozwiązać przed lekcją powtórzeniową. Wśród nich mapy myśli, których rysowanie sprzyja lepszemu zrozumieniu i zapamiętaniu nowych treści. Powtórzenie wiadomości i umiejętności znajdujące się na końcu zeszytu zawiera zadania i mapy myśli dotyczące wszystkich zagadnień omawianych w klasie 7.